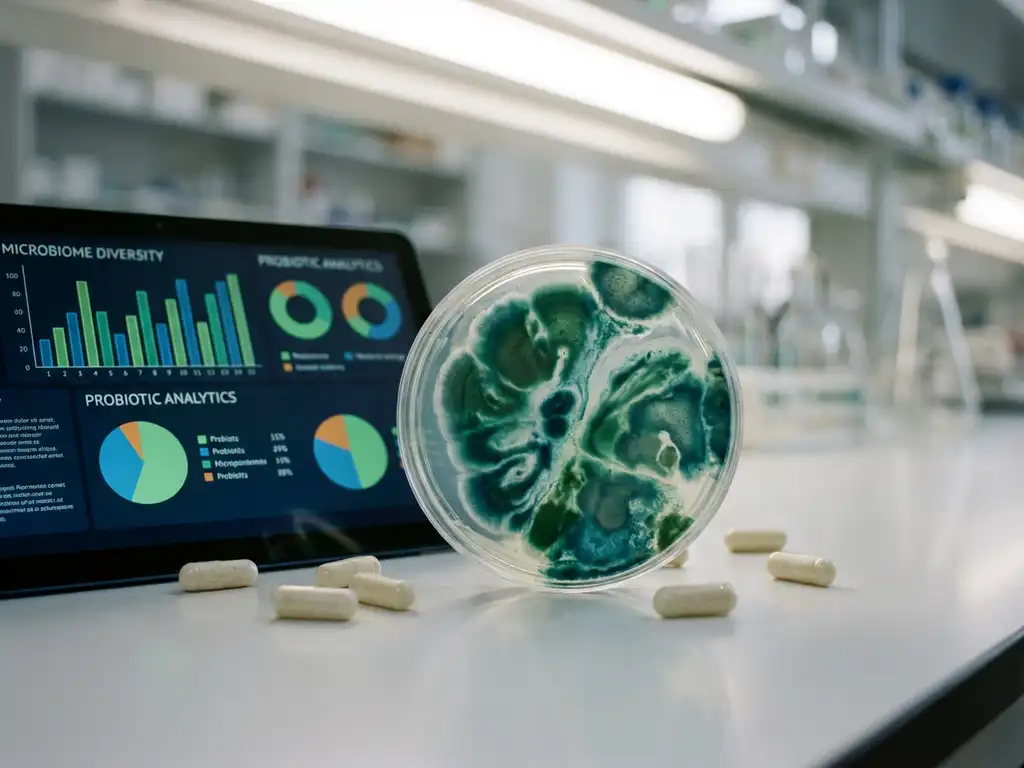
Petri dish with teal bacterial cultures on lab bench beside tablet showing microbiome analysis charts and supplement capsules.

Gut microbiome tests evaluate how prebiotics interact with bacterial communities in the digestive tract, providing crucial insights into product effectiveness before expensive clinical trials. These tests analyse changes in microbial composition, metabolite production, and functional responses to predict real-world outcomes. Understanding proper validation methods helps companies avoid the costly “Valley of Death” between promising lab results and clinical failures.
What are gut microbiome tests and why do they matter for prebiotic validation?
Gut microbiome tests are analytical methods that examine how prebiotics influence bacterial populations, metabolic activity, and functional outcomes within the digestive system. These tests measure changes in microbial composition, short-chain fatty acid production, and specific bacterial responses to determine prebiotic effectiveness.
Traditional testing approaches often fail to capture the complexity of real gut environments. Simple in vitro models lack the microbial diversity found in the human intestine, whilst animal studies don’t accurately translate to human responses due to fundamental differences in gut architecture and bacterial communities.
Effective gut microbiome testing requires maintaining the natural bacterial ecosystem whilst simulating physiological conditions. This includes preserving microbial diversity, replicating appropriate pH levels, and accounting for individual variability that influences prebiotic responses across different populations.
How do traditional prebiotic testing methods compare to advanced microbiome validation?
Traditional methods, including basic in vitro testing and animal models, provide limited predictive value for human clinical outcomes. Animal gut microbiomes differ significantly from those of humans in bacterial composition, transit times, and metabolic pathways, leading to poor translation of results.
Conventional in vitro approaches typically examine only 1–3 bacterial donors, failing to capture the substantial inter-individual variability seen in human populations. These simplified models often miss critical cross-feeding interactions between bacterial species that drive prebiotic effectiveness.
Advanced ex vivo gut simulation technologies address these limitations by maintaining fresh microbial communities under controlled conditions. These systems preserve the original bacterial diversity whilst enabling high-throughput testing across multiple donors, providing statistically robust data that better predict clinical outcomes.
What makes ex vivo gut microbiome testing more predictive than other methods?
Ex vivo testing maintains the original gut microbiome structure and function by using fresh faecal samples under controlled physiological conditions. This approach preserves bacterial diversity and metabolic capacity that would be lost in traditional culture-based methods.
The key advantage lies in capturing immediate microbial responses. Gut bacteria respond to prebiotic interventions within hours, altering their metabolism and composition. Ex vivo systems detect these rapid changes that initiate the progressive health benefits observed in longer clinical trials.
Proper ex vivo validation requires demonstrating that the microbial community remains stable without substrate addition. This is confirmed through parallel no-substrate controls that show maintained bacterial composition, proving the system truly preserves the original microbiome characteristics rather than creating artificial laboratory conditions.
How do researchers measure prebiotic effectiveness through microbiome analysis?
Researchers evaluate prebiotic effectiveness through multiple biomarkers, including bacterial population changes, metabolite production profiles, and functional activity measurements. Key indicators include increased beneficial bacteria, such as Bifidobacterium species, and enhanced short-chain fatty acid production.
Specific measurements focus on bifidogenic effects, where prebiotics selectively stimulate Bifidobacterium growth. For example, galacto-oligosaccharides demonstrate significant bifidogenic activity even at ultra-low doses of 0.5 g, increasing species such as B. adolescentis, B. bifidum, and B. longum.
Metabolite analysis examines butyrate, propionate, and acetate production, which correlate with health benefits. Butyrate-producing bacteria such as Faecalibacterium prausnitzii and Anaerobutyricum hallii serve as indicators of prebiotic success, whilst propionate production is linked to improvements in metabolic health through Bacteroides stimulation.
Why do some prebiotics fail in clinical trials despite promising lab results?
The “Valley of Death” occurs when products showing promise in basic laboratory tests fail during expensive clinical trials costing £400,000–£4 million. This happens because traditional preclinical models lack the complexity and predictive validity needed to forecast human responses accurately.
Inadequate preclinical testing often uses oversimplified models that miss critical factors such as inter-individual variability, microbial cross-feeding interactions, and realistic gut conditions. Products may work for some individuals but not others, yet traditional testing cannot identify responder versus non-responder profiles.
Successful prebiotic development requires validated preclinical models that demonstrate correlation with clinical outcomes. This includes testing across multiple donors (a minimum of 6–8 per cohort), maintaining ex vivo conditions, and measuring comprehensive biomarkers that predict real-world effectiveness before committing to expensive human trials.
How Cryptobiotix helps validate prebiotic efficacy through advanced microbiome testing
We provide validated ex vivo gut microbiome testing through our proprietary SIFR® technology, which bridges the gap between preclinical data and clinical outcomes. Our approach captures immediate microbial responses that predict progressive health benefits observed in clinical trials.
Our comprehensive validation services include:
- High-throughput testing across 6–8 donors per cohort for statistical reliability
- Multi-omics analysis covering taxonomy, metabolomics, and host–microbiome interactions
- Responder/non-responder profiling to understand individual variability
- Integration with digestion models for complex functional food testing
- Biobanking solutions with proprietary cryopreservation methods
Our validated methodology has demonstrated predictive accuracy for clinical outcomes across functional ingredients, pharmaceuticals, and animal health products. We help companies generate mechanistic evidence for regulatory submissions, de-risk clinical trials, and build robust intellectual property portfolios.
Ready to validate your prebiotic’s effectiveness with predictive preclinical data? Contact our team to discuss how our SIFR® technology can accelerate your product development whilst reducing clinical trial risks. Explore our scientific publications demonstrating validated correlation with human clinical outcomes.
Frequently Asked Questions
How many donors should I test to get reliable results for my prebiotic?
For statistically reliable results, we recommend testing across a minimum of 6-8 donors per cohort. This captures the significant inter-individual variability in gut microbiomes and helps identify responder versus non-responder profiles. Testing fewer donors may miss critical population differences that could affect clinical trial outcomes.
What's the typical timeline for ex vivo gut microbiome testing compared to clinical trials?
Ex vivo testing typically takes 2-4 weeks to complete, including sample processing, incubation, and comprehensive analysis. This is dramatically faster than clinical trials, which can take 6-18 months and cost £400,000-£4 million. The rapid timeline allows for iterative testing and optimization before committing to expensive human studies.
Can ex vivo testing predict which individuals will respond best to my prebiotic?
Yes, advanced ex vivo testing can identify responder and non-responder profiles by analyzing baseline microbiome composition and metabolic responses. This helps predict which population subgroups are most likely to benefit from your prebiotic, enabling more targeted clinical trial design and better patient stratification strategies.
What happens if my prebiotic shows mixed results across different donors in testing?
Mixed results often reflect real-world variability and can actually provide valuable insights for product development. We analyze these patterns to identify baseline microbiome characteristics that predict responsiveness, helping you understand your target population better and potentially reformulate for broader efficacy or develop personalized approaches.
How do I know if the ex vivo results will translate to actual clinical outcomes?
Validated ex vivo systems like SIFR® technology have demonstrated correlation with clinical trial outcomes through published studies. The key is ensuring the testing maintains original microbiome diversity, uses appropriate physiological conditions, and measures biomarkers that have established links to health benefits, such as SCFA production and beneficial bacterial growth.